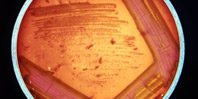

Бактерия долгое время считалась относительно неопасной, но в настоящее время это один из самых страшных внутрибольничных патогенов. Она особенно опасна для пациентов с ослабленным иммунитетом или для пациентов с воспалительными заболеваниями легких. Хотя зона поражения практически любой орган, наиболее распространены инфекции дыхательных путей и крови.
Анализ генома патогена позволил выделить 23 линии происхождения с различными уровнями распространенности. Одна конкретная линия распространена во всем мире и имеет самый высокий уровень связанных с человеком штаммов. Этот тип «Sm6» также характеризуется наличием ключевых генов вирулентности и устойчивости. Конкретная конфигурация генов может способствовать распространению различных подтипов S. maltophilia в условиях стационара, при антимикробном лечении.